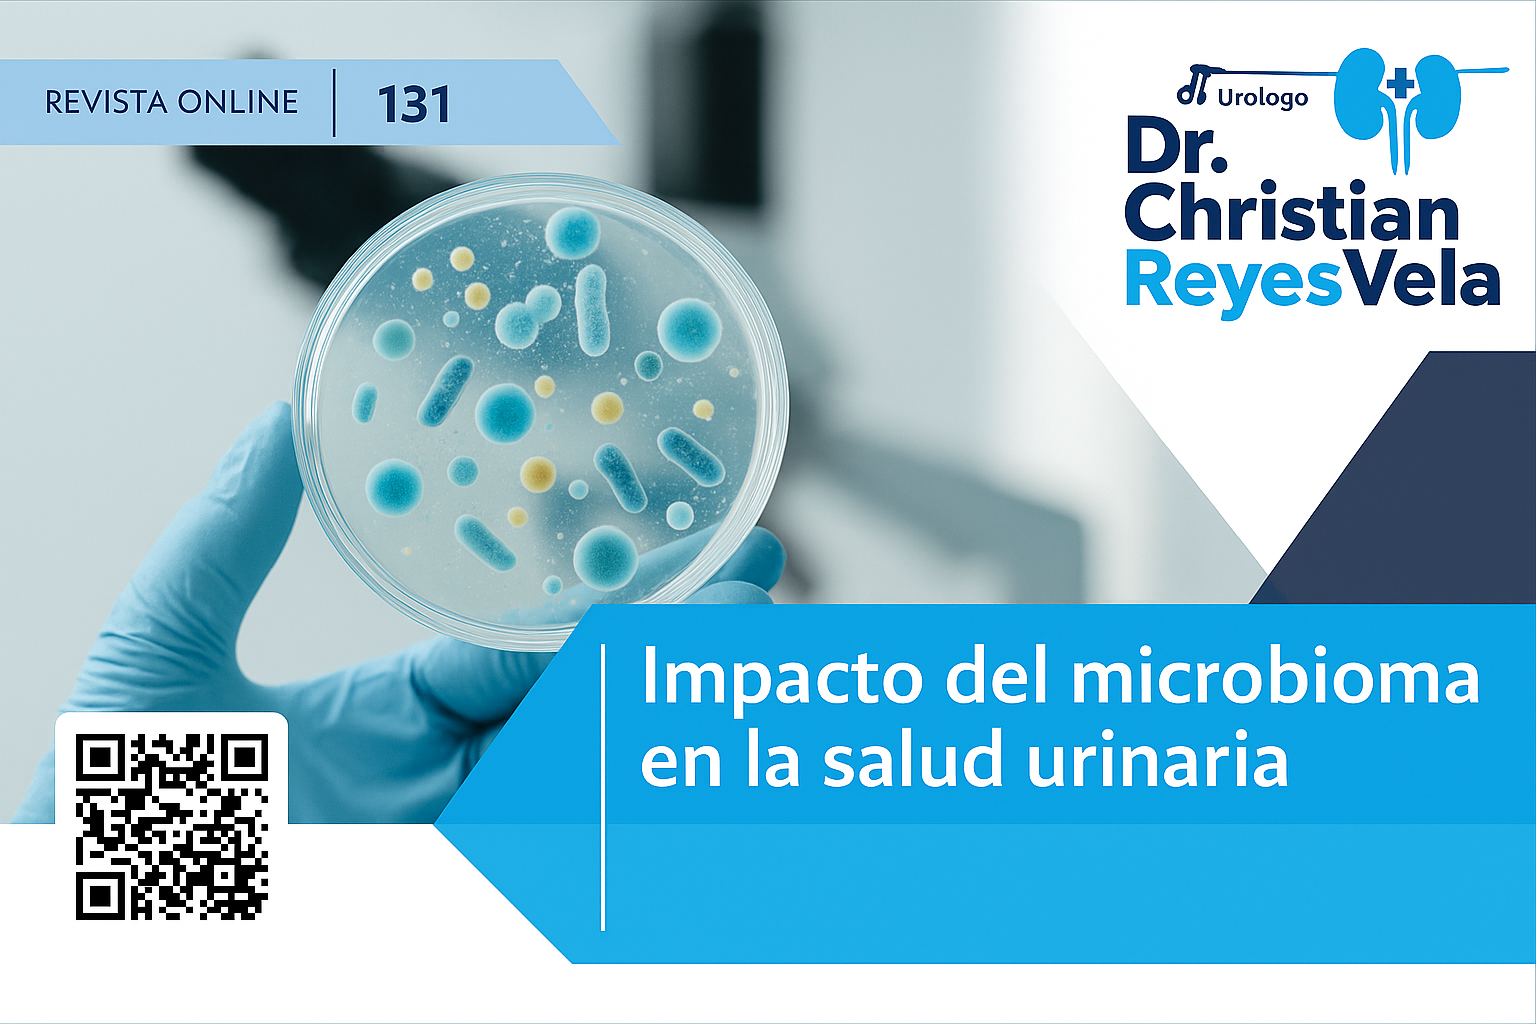

Impacto del microbioma en la salud urinaria
En los últimos años, la medicina ha descubierto que las bacterias que viven en nuestro cuerpo no siempre son dañinas. De hecho, forman parte de un sistema complejo conocido como microbioma, que cumple funciones esenciales para la salud. Aunque solemos relacionarlo con el intestino, hoy sabemos que también existe un microbioma urinario que influye directamente en el bienestar de las vías urinarias.
Durante mucho tiempo se pensó que la orina era completamente estéril, pero estudios recientes han demostrado que contiene pequeñas comunidades de bacterias que ayudan a mantener el equilibrio del sistema urinario. Cuando este equilibrio se rompe, aumentan las probabilidades de infecciones recurrentes, inflamaciones o incluso enfermedades crónicas.
El microbioma urinario también puede desempeñar un papel en problemas como la vejiga hiperactiva, la incontinencia o ciertas formas de prostatitis. Al analizar estas bacterias, los médicos pueden comprender mejor por qué algunos pacientes presentan síntomas persistentes aunque las pruebas tradicionales no muestren infecciones claras.
Cuidar el microbioma urinario está relacionado con hábitos de vida saludables. Mantener una buena hidratación, reducir el consumo excesivo de antibióticos y llevar una alimentación balanceada favorece el crecimiento de bacterias beneficiosas. En algunos casos, incluso se estudia el uso de probióticos diseñados para mejorar la salud urinaria.
Este descubrimiento ha abierto la puerta a tratamientos más personalizados, donde en lugar de atacar de manera general, se busca restaurar el equilibrio natural del organismo. Esto significa menos efectos secundarios y mejores resultados para los pacientes.
El Dr. Christian Reyes Vela ofrece a sus pacientes una visión actualizada sobre el papel del microbioma en la salud urinaria, integrando este conocimiento en las estrategias de prevención y tratamiento.
📍 Hospital Star Médica Luna Parc
📍 Hospital Star Médica Tlalnepantla
📍 Próximamente en Hospital San Ángel Inn, Satélite – Naucalpan, Estado de México
📲 Agenda tu cita fácilmente vía WhatsApp y descubre cómo la ciencia más reciente puede ayudarte a mantener tu salud urinaria en equilibrio.
#MicrobiomaUrinario #SaludUrinaria #PrevenciónUrológica #InfeccionesUrinarias #UrologíaAvanzada #BienestarUrológico #ConsultaUrológica #Microbioma #Prostatitis #VejigaHiperactiva #CuidadoDeLosRiñones #FloraBacteriana #SaludMasculina #AtenciónEspecializada #UrologíaIntegral #CalidadDeVida #InvestigaciónMédica #Probióticos #EquilibrioNatural #DrChristianReyesVela

